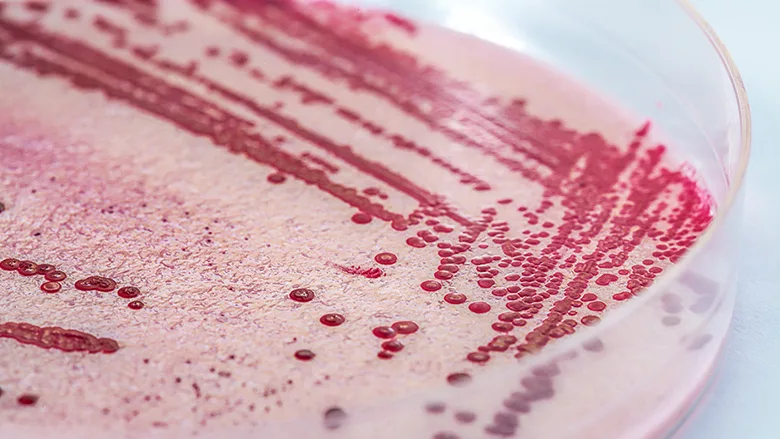
listeria petri dish

A Review of Listeria in the UK Food System
Credit: KatarzynaBialasiewicz/iStock / Getty Images Plus via Getty Images
A recent review published in Foods examines the history of foodborne illness outbreaks caused by Listeria monocytogenes in the UK, as well as the challenges related to the pathogen that food manufacturers must face, to determine potential avenues for future research, surveillance, and public health strategies. The authors note room for improvement in the UK’s L. monocytogenes monitoring systems and industry’s sanitization and Hazard Analysis and Critical Control Points (HACCP) strategies. The authors also recommend a bilateral approach to understanding L. monocytogenes’ role in the UK food system.
According to the review, there were 142 recorded cases of listeriosis in England and Wales during 2019. Of these cases, 17.6 percent were related to pregnant individuals, of which 63 percent resulted in stillbirths or miscarriages. Additionally, the mortality rate for listeriosis cases that were not related to pregnant individuals was 19.7 percent. All published investigations for listeriosis outbreaks in England and Wales in 2017–2019 were linked to food or a food environment.
The review addressed the challenges that food manufacturers face in controlling L. monocytogenes. Notable difficulties relate to the pathogen’s stress tolerance. Specifically challenging is L. monocytogenes’ ability to survive and grow in refrigerated areas, as well as its tolerance to preservation techniques such as salt curing, fermentation, and biocides. In overcoming these difficulties, the review notes the success of adherence to food safety management systems (FSMS) that follow HACCP or ISO 22000 frameworks.
Implemented strategies to control L. monocytogenes contamination in the UK food system include cleaning and disinfection, food processing, infrastructural design, and training of personnel. Processing methods, such as thermal processing and irradiation, can also be utilized to combat the pathogen in food. However, evidence of strain-dependent tolerances has been demonstrated by L. monocytogenes for two processing techniques: pulsed electric fields and high-pressure processing. UK legislation requires that food products are tested for microbial contamination, and suggests that facilities follow ISO guidelines for sampling, enrichment, and identification of L. monocytogenes.
The review provided recommendations for research-led surveillance, including exploration of the virulence capabilities and stress tolerances of L. monocytogenes isolates, as well as meta-analyses of these attributes for all reported isolates. The review also suggests research into the epidemiology of the serotypes and clonal complexes of clinically relevant isolates in order to understand L. monocytogenes’ persistence and entry routes into the food system. The authors believe that these types of studies could also provide insight into the most effective disinfection and processing strategies.
The review also stressed the importance of adopting a detection process for L. monocytogenes that provides rapid results, but is also cost-effective. Currently, test results for the pathogen can take up to five days to process. Finally, the authors suggested future research into bacteriophages, ozone, and UV light as control methods for L. monocytogenes, as well as the detection of antibiotic-resistant strains of the pathogen that are present in the UK food system.
Looking for quick answers on food safety topics?
Try Ask FSM, our new smart AI search tool.
Ask FSM →








